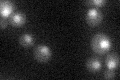
YJR022W
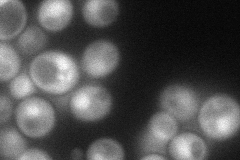
YJR022W
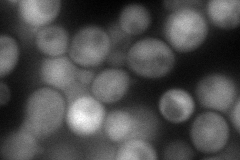
YJR022W

View description
Lsm (Like Sm) protein; forms heteroheptameric complex (with Lsm2p, Lsm3p, Lsm4p, Lsm5p, Lsm6p, and Lsm7p) that is part of spliceosomal U6 snRNP and is also implicated in processing of pre-tRNA, pre-snoRNA, and pre-rRNA
Localization:
Intensity:
Fold change:
Significance:
-
C’ GFP library in SD
nucleus25.26 -
N' NOP1pr-GFP in SD
cytosol,nucleus72.6645 -
N' TEF2pr-mCherry in SD
cytosol117.165 -
N' NATIVEpr-GFP in SD

nucleus28.9322 -
N' TEF2pr-VC and Cyto-VN in SD

#N/A0 -
C’ GFP library in SD+DTT

nucleusN/AN/ANo -
C’ GFP library in SD+H2O2

nucleus24.890.98No -
C’ GFP library in Starvation Media

nucleus47.031.86Yes -
C’ GFP library on the background of Pup2-DaMP

nucleus -
C’ GFP library on the background of CCT mutant

nucleus21.83450.864195No
